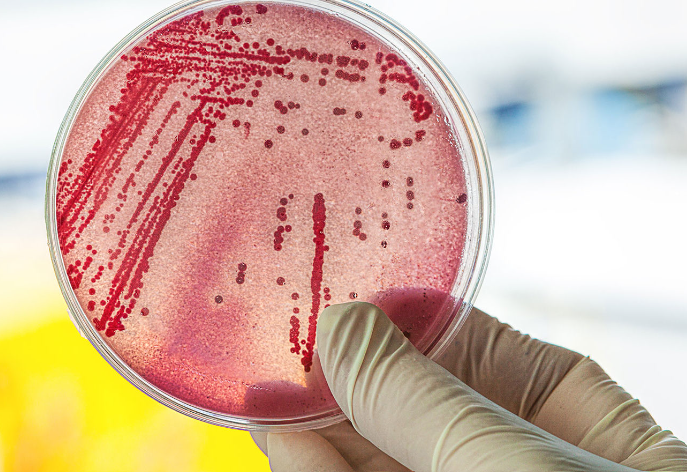

Experiencing an E. coli infection can be a distressing and life-altering event. Beyond the immediate health concerns, there may be significant medical expenses, lost wages, and long-term health issues. In such cases, pursuing legal action can help victims seek justice and secure compensation for their suffering.
Understanding the legal steps involved is crucial for building a solid case. This guide will outline the necessary actions after an E. coli infection, ensuring you are well-prepared to pursue your legal rights. If you are considering filing a lawsuit for E. coli infection, being well-informed about the process and your options is vital.
Identifying the Source of the Infection
The first step in pursuing an E. coli lawsuit is identifying the source of the infection. This can be challenging, as E. coli can be contracted through various means, including contaminated food, water, or contact with infected individuals or animals. Determining the source is critical for establishing liability and building a solid case against the responsible party.
Collecting evidence is essential in this step. Keep detailed records of everything you consumed in the days leading up to your illness and any places you visited. Medical records, lab results confirming the presence of E. coli, and reports from health authorities can provide crucial support for your claim. Documenting your symptoms and their progression can also be helpful.
Seeking Medical Attention and Documentation
Prompt medical attention is crucial not only for your health but also for your legal case. Seeking immediate treatment helps document the severity of your illness and establishes a clear timeline of events. Ensure that all medical visits, diagnoses, treatments, and prescribed medications are thoroughly documented.
These medical records will serve as vital evidence in your lawsuit, demonstrating the impact of the E. coli infection on your health. They can help establish a direct link between the infection and the identified source, strengthening your case. Keeping a journal of your symptoms and how the illness affects your daily life can also be beneficial.
Consulting with a Specialized Attorney
Navigating the legal complexities of an E. coli lawsuit requires expertise. Consulting with an attorney who specializes in foodborne illness cases is essential. They can provide valuable insights into your legal options, help you understand the strengths and weaknesses of your case, and guide you through the legal process.
A specialized attorney will also assist in gathering evidence, filing necessary paperwork, and representing you in court. Their experience with similar cases can significantly increase your chances of a successful outcome. They will ensure that all procedural requirements are met and your rights are protected.
Filing the Lawsuit
Once you have gathered sufficient evidence and consulted with a specialized attorney, the next step is to file the lawsuit. Your attorney will help you draft and file the complaint, which outlines the details of your case, including the nature of the infection, the source, and the damages you seek. The complaint must be filed within the statute of limitations, which varies by state.
The filing process also involves serving the complaint to the defendant, who then has the opportunity to respond. This step initiates the legal proceedings and sets the stage for discovery and negotiations. Your attorney will ensure all necessary documents are filed correctly and on time.
The Discovery Process
The discovery process is a critical phase in an E. coli lawsuit, where both parties exchange information and gather evidence to build their cases. This stage is essential for developing a comprehensive understanding of the facts and preparing for trial. Here are the key components of the discovery process:
- Depositions: Both parties can take sworn statements from witnesses and involved parties. This helps gather detailed information and testimonies that may be used in court.
- Interrogatories: These are written questions each party sends to the other, requiring detailed written responses. Interrogatories help clarify facts and gather specific information relevant to the case.
- Requests for Documents: Each party can request relevant documents from the other side. These documents can include medical records, emails, contracts, and other evidence that supports the case.
- Subpoenas: Legal orders to produce documents or appear for a deposition. Subpoenas ensure that all necessary evidence and testimonies are available.
- Expert Consultations: Attorneys may consult with medical or industry experts to interpret complex information and provide professional opinions that support the case.
- Reviewing Medical Records: Analyzing medical records to document the severity and impact of the E. coli infection, which is crucial for proving damages.
- Witness Interviews: Conducting interviews with witnesses to gather additional insights and corroborate evidence. Witnesses can provide valuable information about the source and impact of the infection.
Settlement Negotiations
Many E. coli lawsuits are resolved through settlement negotiations before reaching trial. During this phase, both parties attempt to agree on compensation without going to court. Your attorney will negotiate to ensure you receive a fair settlement covering medical expenses, lost wages, pain and suffering, and other damages.
Settlements can provide a quicker resolution and reduce the stress and uncertainty of a trial. However, if a fair settlement cannot be reached, your attorney will be prepared to take the case to court and advocate for your rights. Your attorney will guide you on whether a settlement offer is reasonable or if continuing to trial is the better option.
Going to Trial
If settlement negotiations are unsuccessful, the case will proceed to trial. Both sides present their evidence and arguments to a judge or jury during the trial. Your attorney will present your case, cross-examine witnesses, and challenge the defense’s evidence to prove that the defendant’s negligence caused your E. coli infection.
The trial process can be lengthy and complex, but a successful outcome can result in a judgment awarding compensation for your suffering and losses. Your attorney’s expertise and preparation are crucial to achieving the best possible result during this phase. The verdict can include compensation for medical bills, lost income, pain and suffering, and other damages related to the infection.
Post-Trial and Appeals
After the trial, if the verdict is in your favor, the defendant may choose to appeal the decision. This means that the case could be reviewed by a higher court, which can prolong the resolution. Your attorney will continue representing your interests during appeals, presenting arguments to uphold the original verdict.
During this time, staying in close contact with your attorney and providing any additional information they may need is essential. Even after a favorable verdict, enforcing the judgment and collecting the awarded compensation can require further legal action.



